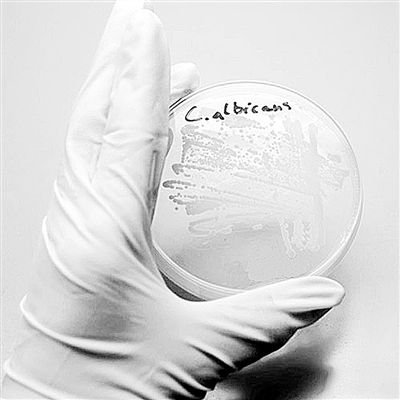

在大多数人身体里,白色念珠菌如同一个“双重间谍”,它平和地活着,但当人的免疫系统受到艾滋病病毒(HIV)或其他病毒侵害,它常常会“叛变”,进而导致疾病发生。
美国约翰霍普金斯大学和哈佛医学院刊登在最新一期的《生物化学》上的一项新研究显示,锁定真菌的一个特定成分可能会将其从凶猛的狮子变成温顺的小猫,最终化敌为友。
感染真菌病的高危人群长期服用抗生素会有副作用,因为抗生素不仅杀死致病的菌种,也杀死正常存于人体的细菌,改变了口腔、肠道及阴道内的微生物平衡,并造成真菌的过度生长。艾滋病患者、接受甾体治疗者及接受化疗者等免疫系统较弱的个体感染真菌病的风险也较高,另外糖尿病患者、年长者及婴儿也是高风险人群。
研究人员说:“对于全身性念珠菌感染的治疗选择是有限的,寻找新药物靶点的一大难点是真菌与人们息息相关,所以在阻击病原体时也伤害到病人。现在,我们已经确定了促使念珠菌感染致病的一个关键功能。如果我们通过药物治疗对其进行限制,它将会使真菌及其存活的机体都健康,同时将念珠菌的伤害力移除。”
念珠菌存活于大多数人的内脏,作为所谓“共生”的无害微生物之一,有时会引起口腔或生殖器的局部感染,例如采用非处方抗真菌药物治疗的鹅口疮。不过,念珠菌一旦有机会突破人体防线,可以越界进入血液,从和平共处转换到攻击的模式,产生长细丝深入组织并摧毁它们。
研究人员说:“不幸的是,现在只有一些抗真菌的药物,而一旦对念珠菌产生耐药性是特别危险的。出于这个原因,我们一直在寻找突破其盔甲的间隙。”
研究人员在念珠菌细胞被称为液泡的部分兴奋地发现了这样一个新缝隙。液泡的主要功能是作为一个嚼碎废物的回收中心,而从先前的研究中发现,一个大家都知道的抗菌药物可以防止液泡酸化,这引起研究人员的怀疑——液泡酸化对形成毒性具有重要作用。该研究小组专注于V-ATP酶,这种酶负责制造许多细胞的隔间,包括液泡,产生酸性。因为人类有一个非常类似的酶,研究人员并不想完全消除它,那样如同以“大锤”猛击众多细胞。相反,他们只追踪该酶的一个组件——亚基a。像在真菌和高等动物中的许多蛋白质一样,有来自不同基因的多个版本的亚基a,这种重复为生物体防止某个基因突变无效时准备的备份。
研究人员首先改造念珠菌细胞,使其只能够使用一个基因子单元的一个或其他版本。正如预期所料,他们发现使用的版本钝化没有效果,而除此之外,其他的只是作为功能的补充。这表明液泡酸化专门依赖于基因的一个版本。这是允许研究人员将V-ATP酶的液泡酸化从许多其他功能中分离,并对其病毒性进行测试的重要一步。当真菌无法酸化液泡,便再也无法形成具有致命特征的细丝。当研究人员将健康的念珠菌注射到小鼠的血液中,几乎所有的小鼠在一周内死亡。相反,当被注射无法酸化液泡的真菌后,小鼠依旧健康存活。
研究人员说,阻断真菌液泡酸化有意想不到的效果,现在实验室已经在使用药物治疗被称为心律失常的心脏疾病。下一步将由美国食品和药物管理局批准,增加阻击致命真菌感染的抗真菌药物的必备药单。